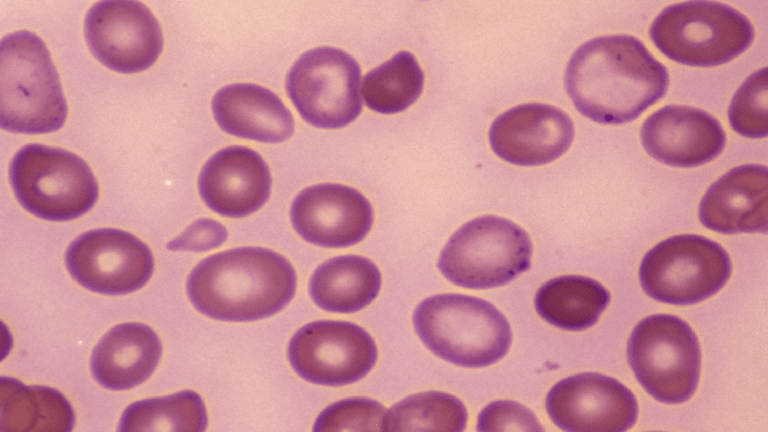

نقص فيتامين B12: ست علامات لاحتمال تعرضك لخطر الإصابة بفقر الدم الخبيث!
يمكن أن يؤدي نقص فيتامين B12 إلى إحداث تغييرات في صحتك الجسدية والعقلية، حيث يقدّم عددا من الأدوار المحورية في الجسم المسؤولة عن كل من العمليات الجسدية والعقلية.
ويمكن أن يسبب نقص الفيتامينات الأساسية، فقر الدم الخبيث. فما هي العلامات الست التي يجب البحث عنها؟.
يوضح موقع Bupa: “فقر الدم الخبيث هو أحد أمراض المناعة الذاتية، تسببه الأجسام المضادة من جهاز المناعة لديك والتي تهاجم أنسجة جسمك، والتي يعتقد أنها غريبة. وهذا يسبب التهابا في بطانة معدتك. عادة، يرتبط البروتين المعروف باسم العامل الداخلي، والذي يتم إنتاجه في معدتك، بفيتامين B12 المنطلق من الطعام الذي تناولته، ثم يحمل الفيتامين عبر جدار الأمعاء إلى الدم. وإذا كنت تعاني من فقر الدم الخبيث، فقد تتضرر خلايا المعدة التي تنتج العامل الداخلي، ما يعني أنه لم يعد من الممكن امتصاص فيتامين B12 ويتطور النقص، ويؤدي إلى فقر الدم”.
ويسرد Bupa ست علامات للبحث عنها:
• الشعور بالتعب الشديد.
• ضيق التنفس حتى بعد القليل من التمرين.
• خفقان القلب.
• الصداع.
• قلة الشهية.
• التهاب في الفم واللسان.
وغالبا ما يتم الخلط بين حالات نقص فيتامين B12 الأخرى، مثل تلك الناجمة عن سوء تناول الطعام، وبين فقر الدم الخبيث.
ويُعتقد أن فقر الدم الخبيث هو اضطراب في المناعة الذاتية يؤذي الخلايا الجدارية في المعدة.
ومع ذلك، قد يحتوي فقر الدم الخبيث أيضا على مكون وراثي له أيضا، ومن المحتمل أن يكون متوارثا في العائلات.
وإذا كان الشخص لا يحصل على ما يكفي من فيتامين B12 من نظامه الغذائي، فقد ينصحه الطبيب العام بتناول المزيد من الأطعمة المدعمة بفيتامين B12 أو تناول مكملات منتظمة.






